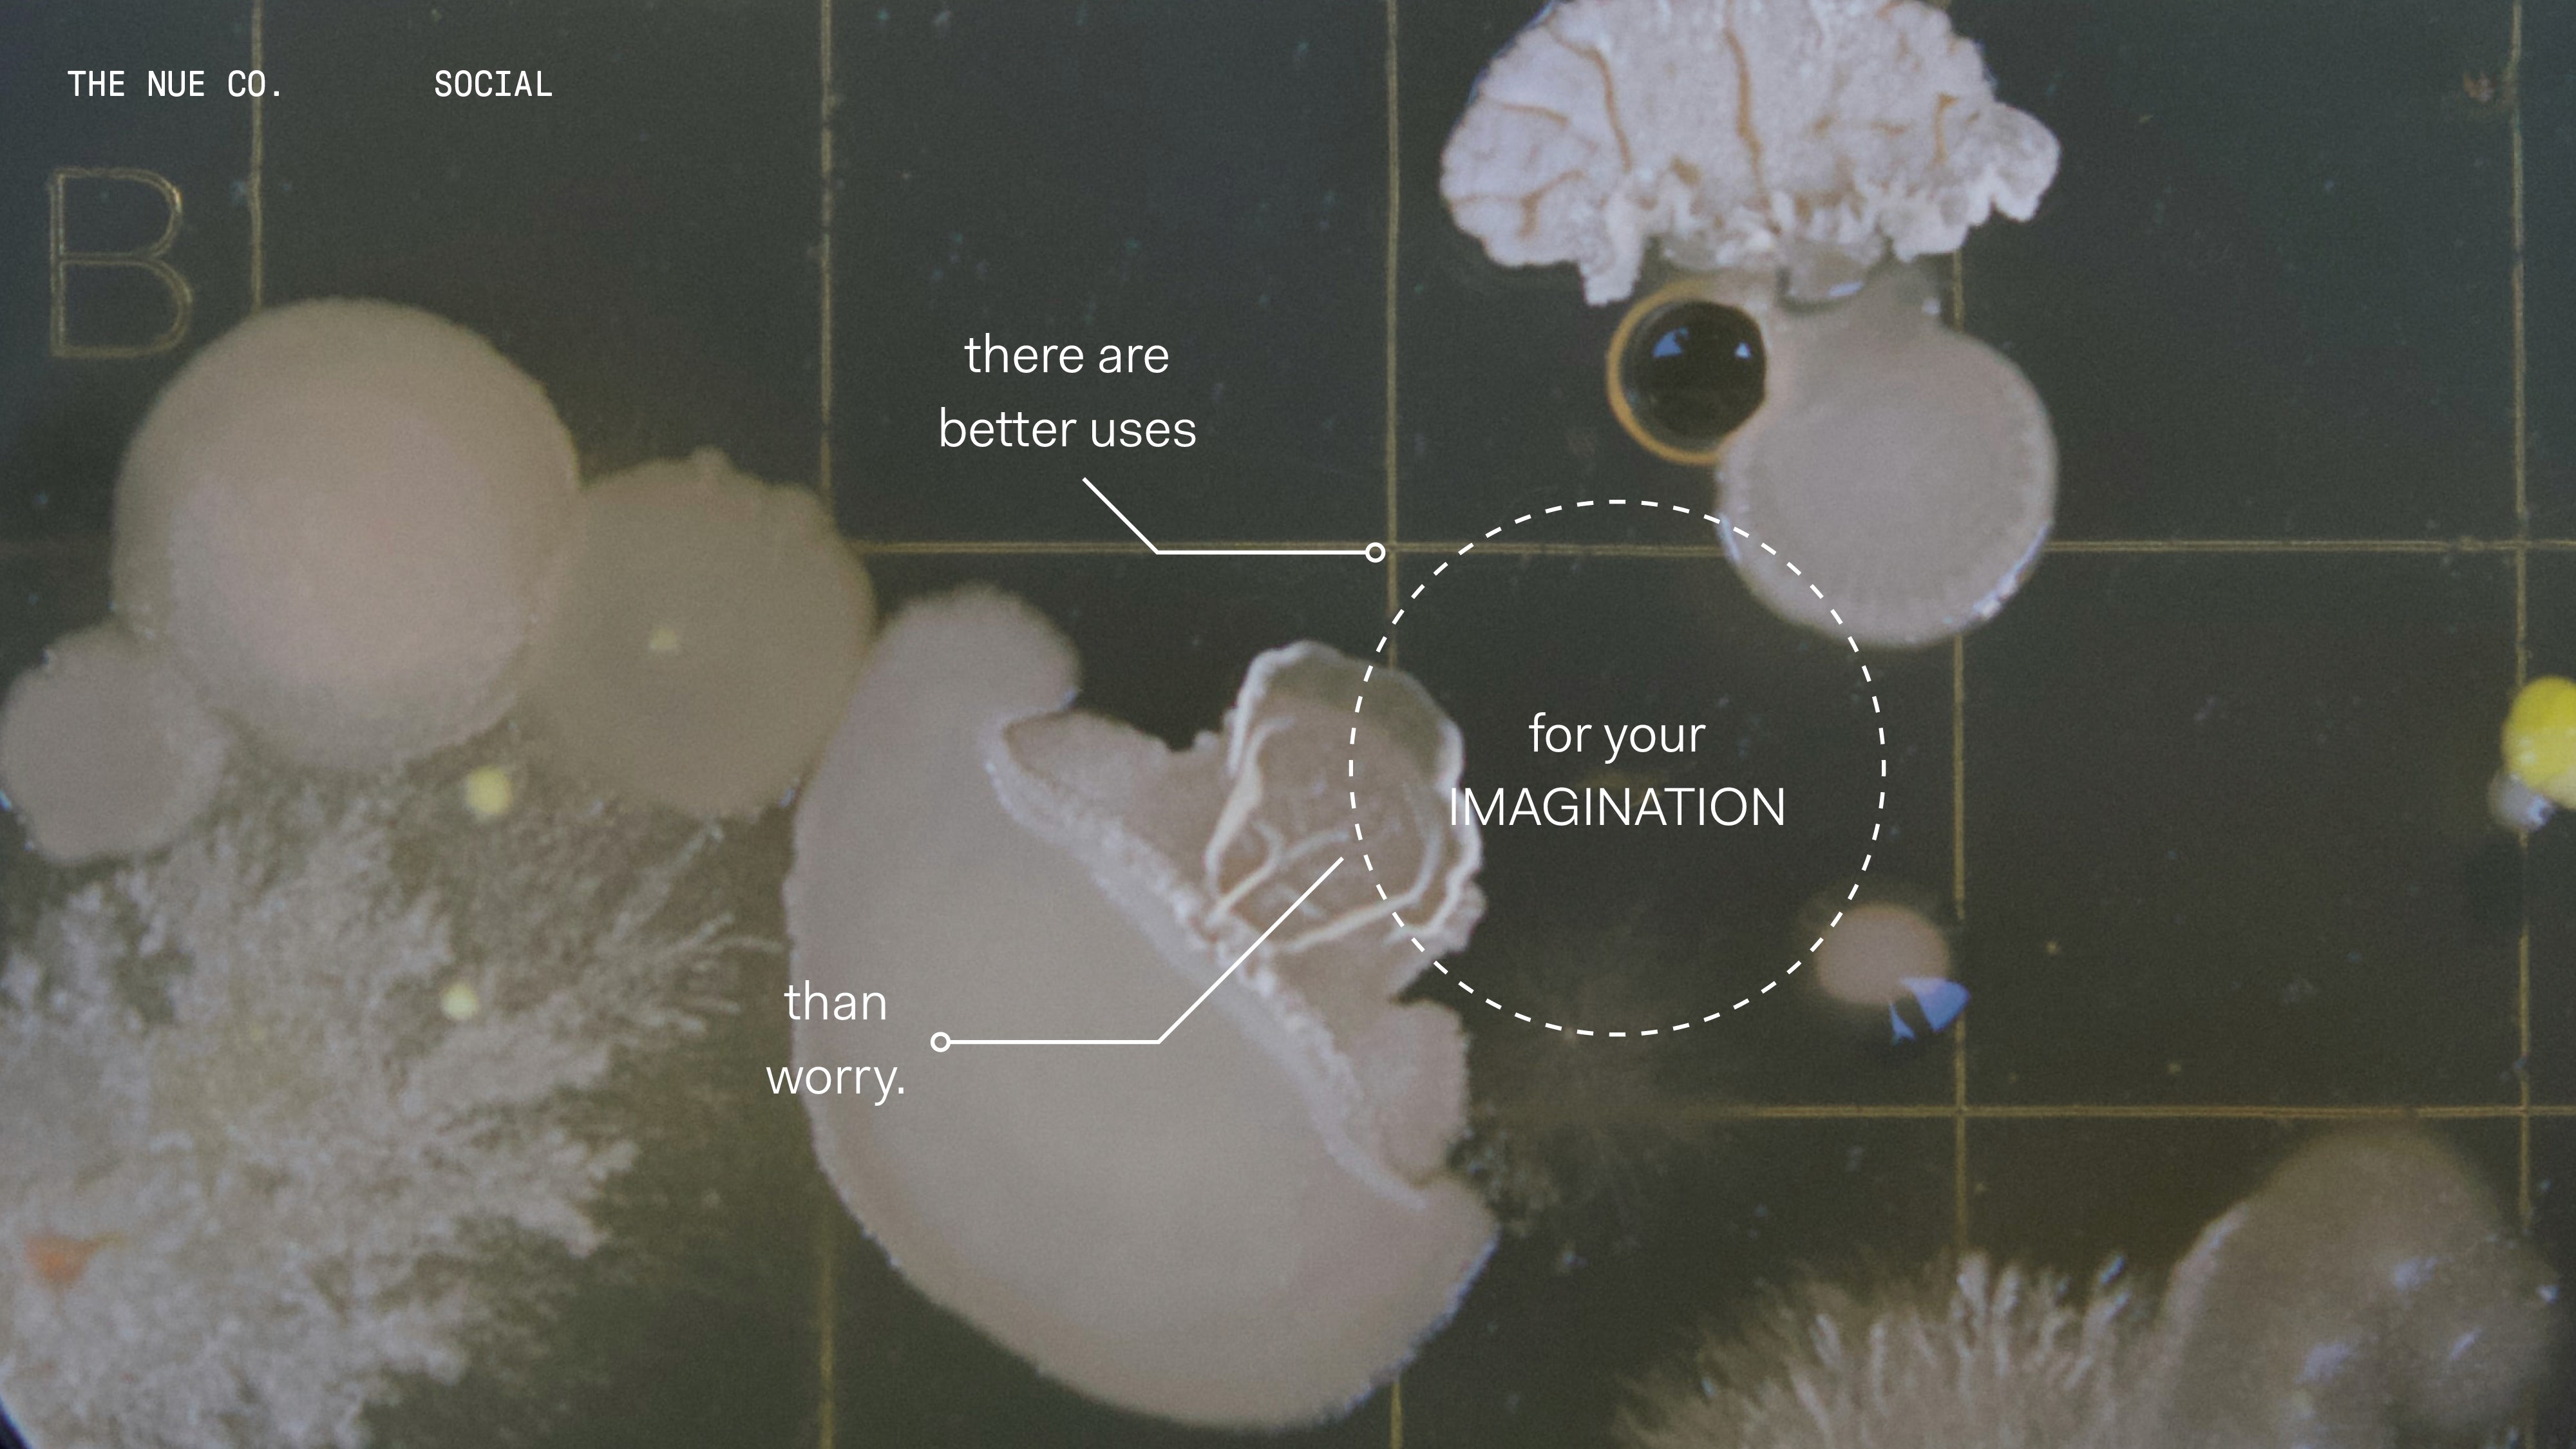

Promoting the new AJ11 retro-release, “Gratitude to the Fam” uses the moment to show Nike’s gratitude to their most loyal fans. The idea centres around a series of activations which celebrate the Jordan family, dropping content and early-access opportunities for fans in the new home of Jordan on the Nike app.